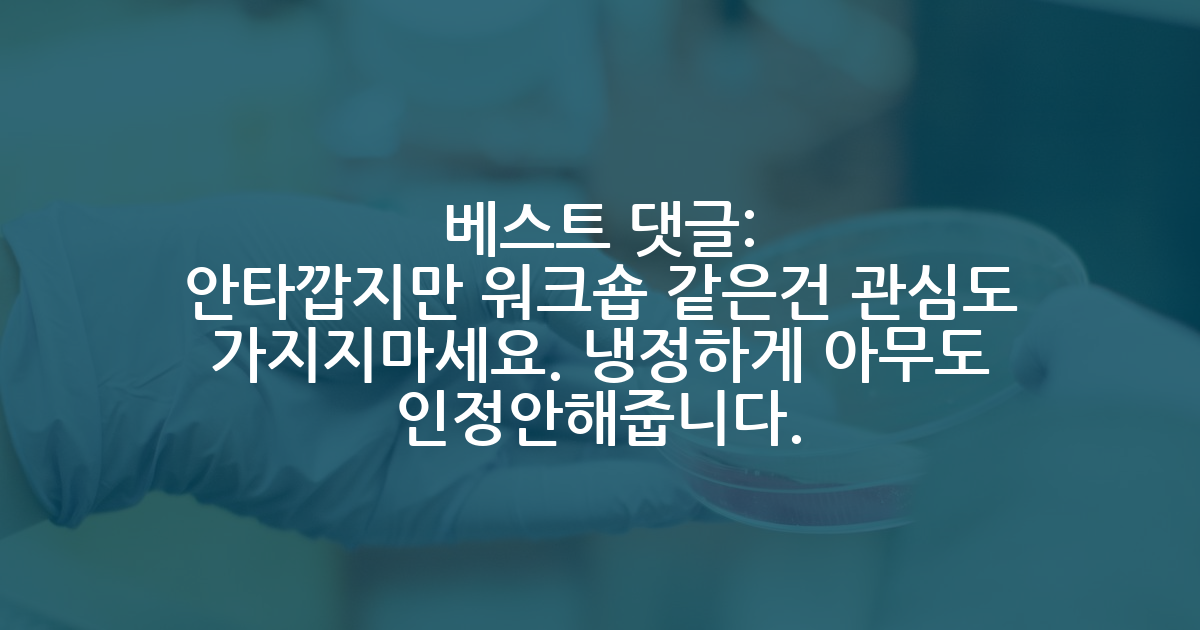

카카오 계정과 연동하여 게시글에 달린
댓글 알람, 소식등을 빠르게 받아보세요
가장 핫한 댓글은?
- 집에가서 만약 한두시간 천천히 조깅하면서 연구관련 생각하면 그건 과연 일을 한걸까요 아니면 논걸까요.
저는 교수지만 예전부터 집에서 멍때리면서 혹은 설겆이같은 집안일하거나 운전하면서 연구아이디어에 대한 생각들을 많이 합니다. 이제는 약간 습관처럼 됐다보니 와이프가 뭐라말할때 흘려들어서 혼나는 때도 많아요.
즉 정말 손기술이 필요하거나 연구실에 붙인 궁둥이와 비례해서 실험결과가 나오는 특수의 경우가 아니면, 본인에 맞춰서 본인한테 가장 좋은 연구습관을 기르시면 됩니다. 저는 정말 빡세게 생각해보고 스스로 확신이 들면 연구시작하는데, 그만큼 연구를 시작하면 대충 어떻게해야할지까지 짜여있어서 학생들한테 명확하게 가이드하면 다들 1년안에 논문이 나오게됩니다. 다만 저도 무슨 도깨비 요술주머니처럼 뚝딱하면 나오는게 아니라 정말 오랜기간 고민해보고 나오는겁니다. 근데 학생들은 뭔 저는 아이디어가 버튼누르면 나오는줄 아는것같더라고요.
연구실에 맨날 대충하는데 똑똑한 동기가있습니다
36 - 아이디어라는게 멍때리다 나오는 사람도 있고 참고문헌 빡빡 찾다가 나오는 사람도 있고 케바케라 남이랑 비교할 필요 없음...
연구실에 맨날 대충하는데 똑똑한 동기가있습니다
17 - 교수도 학생들처럼 한 인간이고 그들도 자존심이란게 당연히 있겠죠.
그들 중에 평소 자존심 내려놓고 사는 사람도 있고 자존심 챙기며 사는 인간들도 있습니다.
친구들 중에 유독 자존심이 쌘 사람 없나요? 그런 친구랑은 어떻게 지내나요? 얘는 그냥 이런 사람인가보다 하면 넘기나요 아니면 싸우나요?
그냥 다 인간관계입니다. 그리고 교수와 학생의 관계는 일반 친구관계 혹은 동료들과의 것과 많이 다르죠. 그럼 그에 맞는 인간관계가 있을겁니다.
보통 교수들은 핵심을 짚고 전반적인 연구의 방향성 확인 및 지도가 주 역할입니다. 물론 교수마다 방식의 차이와 역량의 차이가 있습니다.
그리고 그들이 꼭 찐 전문가라서 학생들에게 특정 분야를 연구하게 하는게 아니에요. 그들도 잘 모르지만 뛰어난 학생과 함께라면 할 수 있다고 생각하는겁니다. 그 결과 학생이 교수보다 그 분야를 더 잘아는건 당연한 이야기구요. 근데... 교수에 따라 혹은 학생에 따라 그 결과가 해피엔딩이 있고 새드엔딩도 있습니다. 누구 하나의 문제는 아니에요.
'내가 잘 지도해서 이런 결과가 나왔다.' 혹은 '다 알지 못해도 그래도 어느 정도는 안다' 라는 마음이 교수한테 있을 수 있고
'내가 다했지 너가 다했냐?' '내가 너보다 더 잘 아는데 내가 왜 너의 말을 들어?' 라고 생각하는 학생도 있습니다.
중요한건 학생의 입장에서 그런 마음이 든다면 마음을 잘 다스리길 바랍니다.
상급자에 대한 하급자의 그런 마음이 언제가는 세어나오는데 이게 누적되면 실력과 관계없이 인생이 꼬여들어갑니다. 그리고 평판이 만들어지죠.
뛰어난 실력이 있으면 좋지만 꼭 그게 한 인간의 성공을 담보하지 않습니다.
똑똑한 사람보다 엉덩이 무거운 사람이 논문을 더 잘쓰듯, 이런 마음의 파도를 잘 다스리는 사람이 성공적인 커리어를 만듭니다.
왜 이렇게 권위적이고 자존감 높지 않고 자존심만 많은 교수가 많지..
20 - 상급자를 평가하려 하지 마요.
아무리 못난 상급자라 할지라도 배울게 있습니다.
열심히 배우세요.
왜 이렇게 권위적이고 자존감 높지 않고 자존심만 많은 교수가 많지..
27 - 교수님이 교신저자로서 현명한 결정을 하셨다고 생각합니다.
원래 마감 직전에 논문 제출 엎어지는 게 흔한가요..?
23 - 랩회식 안시켜주면 또 ㅈㄹ
교수들의 회의 없는 회의비 지출
28 - 이래서 회식 각출해야함
교수들의 회의 없는 회의비 지출
13 - 분야가 달라도 공동연구 한적 없어도 회의는 가능해요
교수들의 회의 없는 회의비 지출
28 - 분야가 다르고 공동연구 기록 없음 만나서 가볍게 논의 하면 안 되???
교수들의 회의 없는 회의비 지출
16 - 아가야 너같은 10선비들때문에 탁상행정이라는 말이 나오는거야. 네 인건비도 9 to 6 출근하고 받아가는거지? 아 물론 출퇴근부 도장 찍고 연구기록 매일 남겨야돼 ^^
교수들의 회의 없는 회의비 지출
29 - 너라도 이 불합리함을 해결하기 위해 회식때 너가 먹은건 너가 계산하자ㅇㅇ 그게 첫걸음이지~ 그건 또 싫지?ㅋ
교수들의 회의 없는 회의비 지출
23 - ㅇㅇ 연구비 자체를 자기돈이라고 생각하는 교수들 졸라많음.
사용처에 제약이 있는데 그걸 자기돈이라고 생각하는게 웃긴일이지ㅋㅋㅋ
우리교수는 입이 고급이라 ㅈㄴ비싼 중식당, 양식당만 긁고다녀서 회의비만 1년에 2000만원 나온적도 있음
교수들의 회의 없는 회의비 지출
13 - 우물안 개구리 마인드
같은 분야여야 회의 가능하다? ㅌㅋㅋㅋㅋ 웃음만 나옴 작고작은 본인 분야에서만 사세요. 교수로 있다보니 진짜 말도 안되는 곳에서도 협력하자고 연락오고 듣다보면 가능하다고도 생각됨
연구비는 그렇게 다 따오는거임. 그리고 나라에서도 그런 협력 창출을 장려하고 있다.
교수들의 회의 없는 회의비 지출
18
해외 컨퍼런스 워크샵에 논문내는게 의미가 없는게 맞을까요
2026.01.23
학회 갔을땐 '어 왜 proceedings에 내 논문이 없지?' 라고만 생각하고 말았는데
이곳저곳 서칭을 해보니 실적 측면에선, 유명 워크샵 외엔 '그냥 있으면 나쁘지 않은데 없어도 무방한 수준' 이라고 정리할 수 있겠더라구요.
왜 교수님은 이런점에 대해 말씀을 안해주셨을지 잘은 모르겟는데 (제가 여쭤보지 않았으니 말씀을 안해주셨을듯)
뭐.... 'ieee 학회 논문 스타일로 논문 작성해보고, 현재 연구 내용에 대해 정리 해봤다'라고 생각하면 잃은건 없잖아요? 제돈내고 해외갔다온것도 아니니깐요.
논문 다 써주시는 교수님 김GPT 20 40 24094
드러내고 학벌주의자인 교수들도 있긴함 김GPT 45 40 16642-
17 39 11353 -
12 10 3540
논문리젝 후 교수님 잠수 김GPT 13 9 10998
교수님과의 의견 차이 김GPT 5 13 2258
공저자 김GPT 0 9 918
논문 실적 저조한데 해외 포닥 지원 김GPT 2 7 4166-
9 17 2660 -
104 42 12491 -
144 36 112225
저는 연구실 생활이 너무 행복합니다.. 명예의전당 287 45 73120
베스트 최신 글
베스트 최신 글
- 한 분야에 흔히 말해 top 몇 안에 든다는 교수님은 어떻게 알 수 있나요?
5528 - 지방대 자대 박사학위를 걱정하는 이들에게
7529 - 졸업 축하 파티 비용을 학생이 부담하는게 맞나요?
3848 - 동기가 퇴근을 안해요,,
8938 - 기업과 교수 연봉 차이가 어느정도인가요?
10939 - 교사랑 교수 비교하는것 부터가 얼마나 아카데미가 나락으로 가는지를 보는거 같음
6018 - 교수가 대학원석사 졸업 을 안시키는 이유가 도대체 뭘가요
5405 - AI 박사 이후 연구직 취업 워라밸
4982 - 임용 시 공저자가 주는 이미지
5258 - 대학원 생활은 온탕냉탕 반복 같아요
3843
🔥 시선집중 핫한 인기글
- 저 MIT EECS 합격한건가요?
14 - 요새 미국 포닥 모두 힘든건가요 아님 제 능력이 부족한걸까요?
5 - 봉사 이런거 다 소용없네요…
11 - 주저자 논문을 써보고 싶은 학부 저학년들에게
205 - 지거국 교수 됐다고 띄워주는거 웃기네
145 - 아무리 강사라도 상명대 출신이 서울대 교단에 서는 건 말이 안되지 않나???
144 - ㅅㅅ 박사도 있나요?
24 - 교사랑 교수 비교하는것 부터가 얼마나 아카데미가 나락으로 가는지를 보는거 같음
28 - 졸업 축하 파티 비용을 학생이 부담하는게 맞나요?
14 - 교수가 되고 싶다는 생각
15 - AI를 개똥같이 쓰는 인간을 보면 화가 납니다
21 - 석사 자퇴 사유인가요?
10 - 실험실 내 원치 않는 이성 접근 때문에 미치겠습니다
3
최근 댓글이 많이 달린 글
- 김박사넷 유학교육 X ETS - 미국 대학원 유학 웨비나
77 - 미국 박사 CS 인터뷰 받으신 분들?
18 - 미국 박사 2년차 워라벨이 대한 단상
19 - 원래 이렇게 합격 발표가 늦나요
13 - 박사 진학에 관련된 고민입니다..
13 - 왜 이렇게 권위적이고 자존감 높지 않고 자존심만 많은 교수가 많지..
24 - 교수들의 회의 없는 회의비 지출
46 - 해외 컨퍼런스 워크샵에 논문내는게 의미가 없는게 맞을까요
13 - 무급 학부생분들
9 - ai시대에 박사의 가치는 더 올라가는게 맞지 않나?
9 - 교수가 창업을 하는 이유가 대체 뭔가요??
21 - 카이스트 전전 회로연구실 합격 가능할까요? 추가 질문도 드립니다
8 - 랩실 인간관계
8

2026.01.24
대댓글 1개
2026.01.23
대댓글 1개
2026.01.23
2026.01.23
대댓글 1개